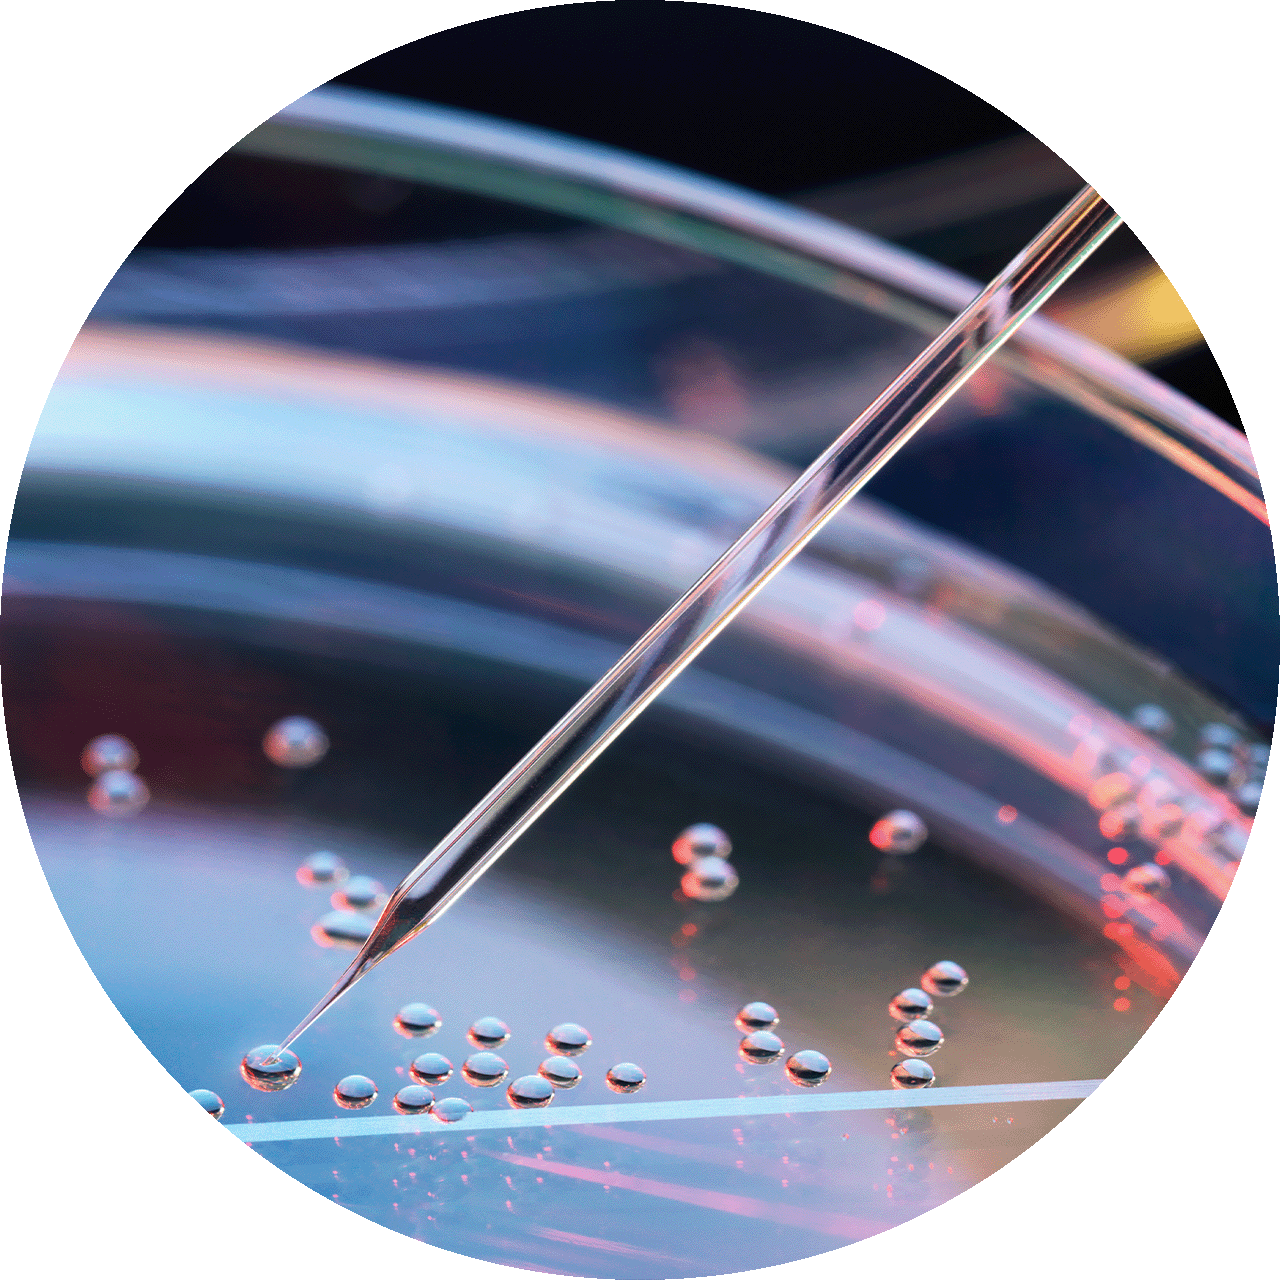
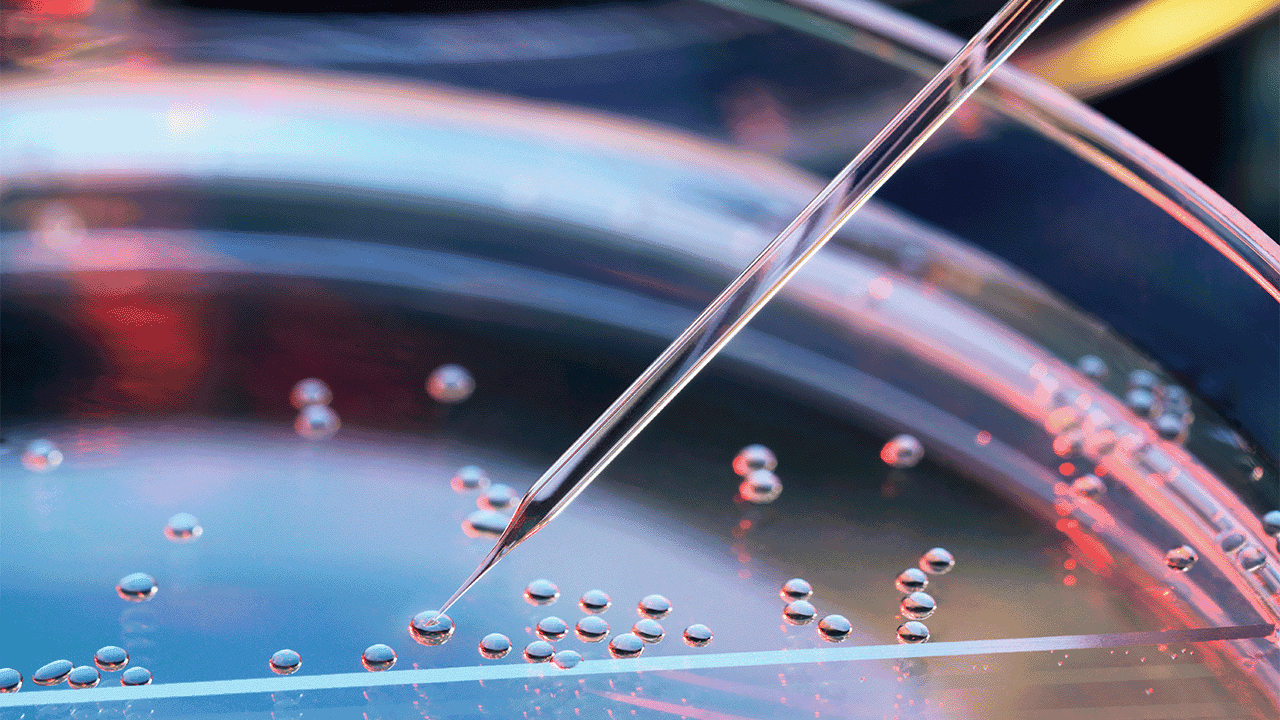

In den meisten Fällen wird eine Schuppenflechte allein durch ihr Erscheinungsbild von Ihrem Arzt / Ihrer Ärztin diagnostiziert werden. In der Regel wird Ihr Hausarzt / Ihre Hausärztin Sie zur genaueren Abklärung an einen Dermatologen / eine Dermatologin überweisen.
Bevor weitere Untersuchungsschritte für die Diagnose und Beurteilung des Schweregrades der Schuppenflechte erfolgen, sieht sich Ihr Arzt / Ihre Ärztin diese Punkte ganz besonders genau an1:
Wenn erforderlich wird eine kleine Hautprobe (Biopsie) entnommen, um andere Erkrankungen, wie z. B. ein Hautekzem, ein T-Zell-Lymphom, eine Knochenerkrankung (Paget-Krankheit) oder auch Arzneimittelreaktionen auszuschließen.
Wenn das Auftreten Ihrer Hautkrankheit mit Halsschmerzen einherging, entnimmt Ihr Arzt / Ihre Ärztin möglicherweise eine Tupferprobe aus dem Rachen, um sie auf Bakterien zu testen.
Wenn Sie Schmerzen in den Gelenken haben, wird der Arzt / die Ärztin wahrscheinlich eine Blutprobe entnehmen, um zwischen rheumatoider Arthritis, Psoriasis-Arthritis und anderen möglichen Erkrankungen mit Gelenkbeteiligung zu unterscheiden.
Das Kennen und Verstehen des Schweregrades Ihrer Schuppenflechte ist ein wichtiger Schritt, um den optimalen Behandlungsplan gemeinsam mit Ihrem Arzt / Ihrer Ärztin zu finden. Zur Beurteilung des Schweregrades werden verschiedene Aspekte berücksichtigt, die mit unterschiedlichen Verfahren bestimmt werden. Die Einteilung des Schweregrades basiert auf drei Werten: BSA (Body Surface Area), PASI (Psoriasis Area and Severity Index) und DLQI (Dermatology Life Quality Index)3,4.
Der BSA-Wert gibt den Prozentsatz der von Schuppenflechte befallenen Körperoberfläche an 4. Die Größe der eigenen Handfläche entspricht ungefähr einem Prozent der Körperoberfläche. Liegt der BSA-Wert unter drei Prozent, so spricht man von einer leichten Schuppenflechte. Ein BSA-Wert von drei bis zehn Prozent wird als mittelschwere Schuppenflechte eingestuft, und ab einem BSA-Wert von mehr als zehn Prozent wird es als schwere Schuppenflechte eingestuft5.
Der DLQI ermittelt die persönliche Beeinträchtigung der Lebensqualität durch die Schuppenflechte4. Mit dem Fragebogen zur Lebensqualität werden das Ausmaß der gesamten körperlichen Belastungen sowie das seelische Befinden innerhalb der letzten sieben Tage beurteilt. Der Fragebogen besteht aus zehn Fragen zu Beeinträchtigungen in Alltag, Freizeit, Schule, Arbeit und zwischenmenschlichen Beziehungen. Jede Frage wird mit einer Punktzahl zwischen 0 und 3 bewertet, so dass die Gesamtzahl zwischen 0 (keine Beeinträchtigung) und 30 (maximale Beeinträchtigung) liegt. Über 10 Punkte bedeutet, dass die Schuppenflechte einen starken Einfluss auf die Lebensqualität hat, über 20 Punkte sogar einen sehr starken Einfluss4.
Der PASI-Wert ergibt sich aus dem Prozentsatz der betroffenen Körperoberfläche und dem Schweregrad der Hautveränderungen3. Es werden sowohl die betroffene Fläche als auch die Ausprägungen der Schuppen erfasst, aufgeteilt nach den vier Körperregionen Kopf, Rumpf, Arme und Beine. Jede Region wird einzeln bewertet, anschließend werden die vier Einzelwerte addiert.Gesunde Menschen haben einen PASI von 0, der theoretisch mögliche Höchstwert liegt bei 72.
Grundsätzlich bestimmen Ihre Ärzte / Ärztinnen Ihren PASI-Wert. Dieser gibt allerdings nur die ärztliche Einschätzung des Schweregrades der Erkrankung wieder. Denn auch ein niedriger PASI-Wert kann für die betroffene Person eine starke Einschränkung der Lebensqualität bedeuten. Zudem berücksichtigt der PASI-Wert nicht ausreichend den Befall besonders kritischer Körperstellen, z. B. der Handflächen. Deshalb sollte zusätzlich zum PASI die Lebensqualität der Betroffenen mit einem Fragebogen erhoben werden. Oft wird hierfür der Fragebogen DLQI verwendet 6.
Nach Durchführung der Diagnoseverfahren lässt sich der Schweregrad je nach erreichter Punktzahl definieren4,6,7:
Leichte Psoriasis | BSA und PASI und DLQI nicht über 10 |
Mittelschwere bis schwere Psoriasis | BSA oder PASI über 10 und DLQI über 10 |
Aber auch wenn BSA oder PASI unter 10 liegen, kann dennoch eine mittelschwere bis schwere Schuppenflechte vorliegen. Dies ist der Fall, wenn der DLQI über 10 ist und einer der folgenden Fälle zutrifft4:
Besprechen Sie Ihre Schweregradeinschätzung gerne mit Ihrem Arzt / Ihrer Ärztin. Im Rahmen der Diagnosestellung wird sie/er den Schweregrad ihrer Psoriasis ermitteln.